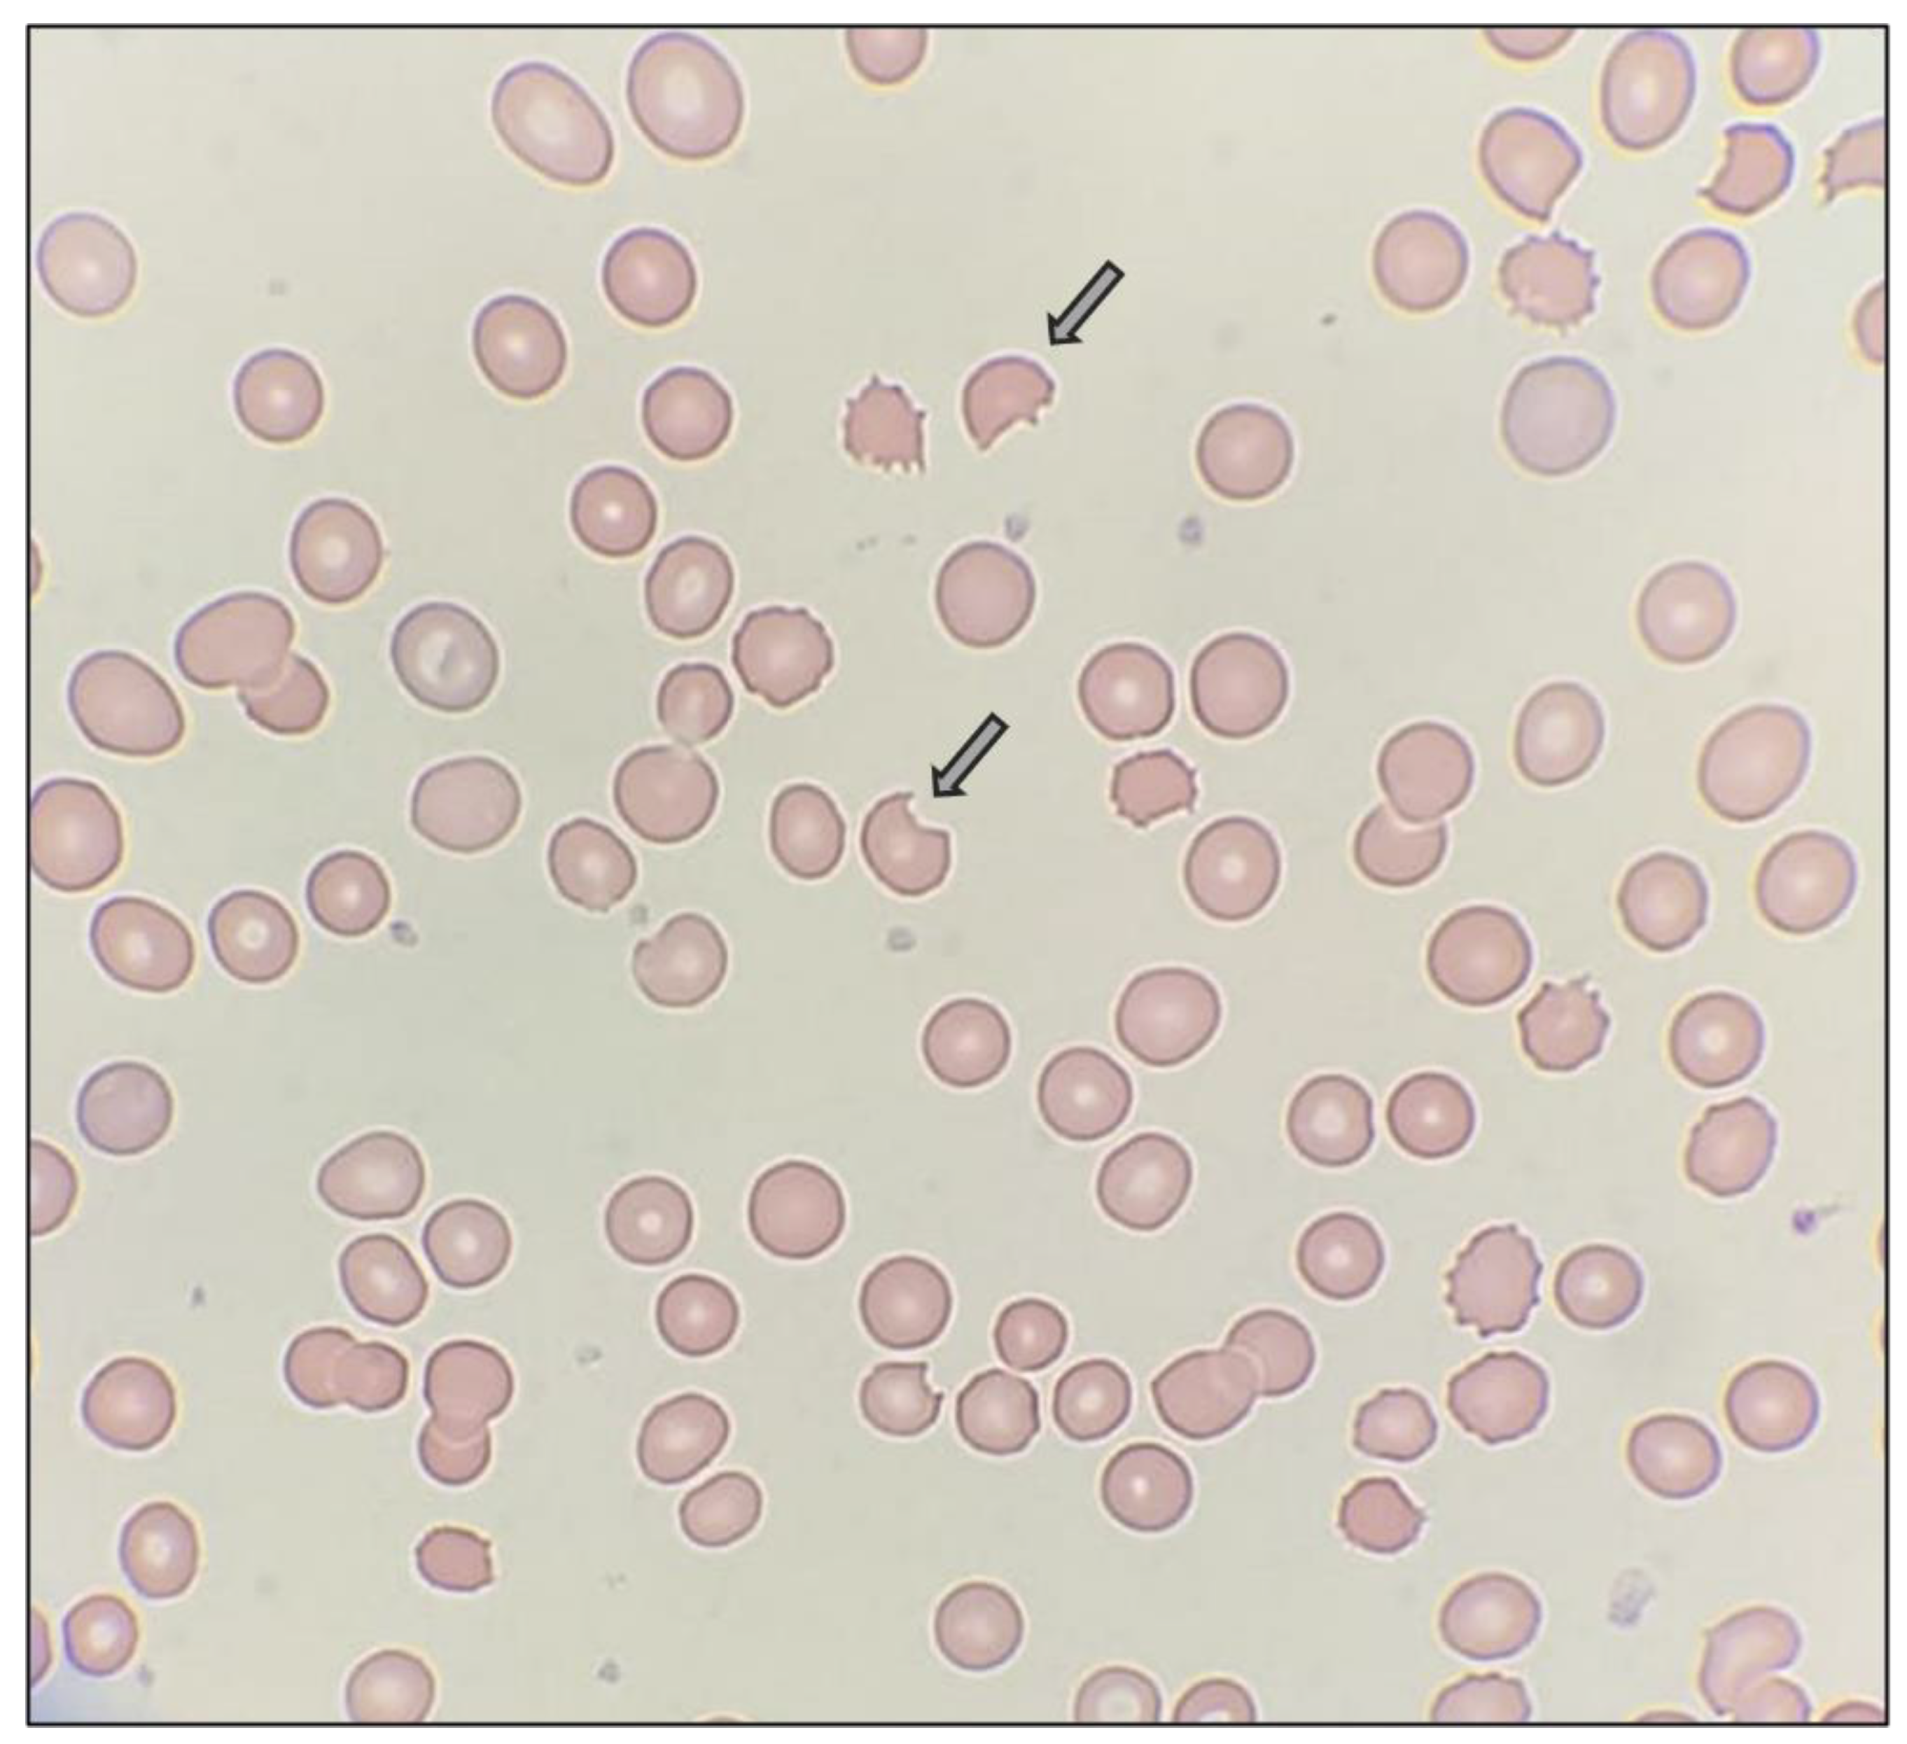
Preprints 96340 g001

Introduction
The glucose-6-phosphate dehydrogenase (G6PD) deficiency is the commonest enzyme deficiency worldwide, [
1] but is considered as a rare disorder with an overall prevalence of less than three percent in Sri Lanka. [
2] Prevalence of the G6PD deficient population is significantly higher in areas where malaria is endemic in Sri Lanka, compared to non-endemic areas [
3].
Patients with G6PD deficiency are usually asymptomatic until they are exposed to an oxidative agent. We report this case where a previously unidentified G6PD deficient patient presented with acute hemolysis following ingestion of Acalypha indica (Kuppamenia in Sinhala).
Case Presentation
A 65-year-old South Asian male patient presented with acute onset of jaundice and hematuria for 3 days after consuming a “mallum” dish (A Sri Lankan dish made by raw leaves and coconut kernel) made by “Kuppamenia” (Acalypha indica). That was the first time he consumed “Kuppamenia”. He denies intake of other drugs or food that can lead to hemolysis. There was no significant past medical history or family history. On examination, the patient was pale and icteric on admission. His SpO2 on air was 96% and had no peripheral cyanosis. His blood pressure was 100/70 mmHg, pulse rate was 92 beats per minute and respiratory rate was 15 breaths per minute. He was conscious, rational, and other system examinations were normal.
Laboratory workup showed anemia and other features suggestive of hemolysis (
Table 1). A blood sample was sent for blood picture analysis (
Figure 1) which showed red cell changes suggestive of hemolytic anemia probably G6PD deficiency.
He was closely monitored for drop in oxygen saturation and was acutely managed with blood transfusions for the anemia (3 units of packed red cells) and started on folic acid. His symptoms were resolved, and urine color returned to normal within 3 days. He was discharged after his clinical features subsided, and he was educated on a list of food items and drugs that can induce hemolysis. A clinic follow-up was arranged after 3 months to confirm G6PD deficiency. His methemoglobin reduction test (Brewer’s test) (
Figure 2) was positive and the G6PD level was 0.162 IU/g Hb (6.5 – 13 IU/g Hb).
Discussion
G6PD is an enzyme that is present in the hexose monophosphate pathway (HMP). It is the only pathway which produces nicotinamide adenine dinucleotide phosphate hydrogen (NADPH) in red blood cells (RBC) [
4]. When a RBC is exposed to oxidative stressors, glutathione act as an antioxidant and becomes oxidized. A particular cell has only a limited number of glutathione molecules and once they are oxidized, they should be converted back to its reduced state, in-order to regain its antioxidant ability (
Figure 3). This requires NADPH for this conversion. Since the HMP pathway is the only pathway that produces NADPH in RBCs, patients who have G6PD deficiency do not have the ability to revert their oxidized glutathione to its reduced state which leads to red cell destruction.
Acalypha indica, (“Kuppamenia” in Sinhala) is a tropical plant which is found in temperate and tropical regions, primarily along the equatorial line. [
5] From ancient times it has been used in herbal medication remedies and some people in South Asian countries use it as a dietary component in their diet (as mallum or kanji).
Many research evidences suggest that
Acalypha indica contains many phytochemicals like cyanogenic glycoside – Acalyphin, Acalyphamide, Alkaloids, Catechol, Sterol, Flavonoids, Saponins which have different biochemical impact on humans and other animals [
6,
7]. Most of these chemicals are antioxidants such as flavonoids (naringin, quercitrin and hesperidin dan kaempferol) and tannins [
8].
Due to this antioxidant ability it is concerned that, it has the capacity to serve as anti-helminthic, anti-inflammatory agent, anti-bacterial, anti-cancer, anti-diabetic, anti-hyperlipidemic, anti-obesity, anti-venom, hepatoprotective, hypoxia and wound healing medicine [
5]. Even though, there are limited literature, it is commonly used in Aurvedic medical remedies in Sri Lanka. Out of all those phytochemicals, it has been documented that quinine, tectoquinone and 2 methyl anthraquinone has the capacity to induce some oxidative stress to the humans [
9], which can lead to acute intravascular hemolysis (
Figure 3) and methemoglobinemia [
10,
11].
Only few cases of acute hemolysis have been reported from Sri Lanka, India, Thailand, and Mayotte island [
12,
13,
14]. When investigating they all had G6PD enzyme deficiency. Many laboratory studies have been done to assess the toxicity level of this plant, using low to very high doses of
Acalypha indica extract in rats, and have found it to be non-toxic to them but for humans [
15]. None of these articles have reported the acute dose and purity of the extract that can induce hemolysis.
Conclusion
Acalypha indica is a well-known plant that has an antioxidant capacity, and it is widely used as a medical remedy in South Asia. The amount of intake and the duration seems to have a link with the prognosis of the clinical outcome. Further studies should be conducted to validate which phytochemical/s are responsible for inducing oxidative stress and the upper level that can induce the toxicity. Moreover, this plant should be included in the “possible avoidable food and drug item list” of the G6PD deficiency patients since this plant is commonly consumed in South Asian countries.
Acknowledgments
We thank the patient, staff of the medical unit, Colombo North Teaching Hospital, Ragama, for their help in the management of this patients, and the Department of Haematology of the Faculty of Medicine, University of Kelaniya, Sri Lanka.
Conflicts of Interest
We declare no competing financial interests.
References
- Nkhoma ET, Poole C, Vannappagari V, Hall SA, Beutler E. The global prevalence of glucose-6-phosphate dehydrogenase deficiency: A systematic review and meta-analysis. Blood Cells, Mol Dis [Internet]. 2009;42(3):267–78. Available online: https://www.sciencedirect.com/science/article/pii/S1079979609000059.
- Gunawardena S, Kapilananda GMG, Samarakoon D, Maddevithana S, Wijesundera S, Goonaratne L V, et al. Prevalence of G6PD deficiency in selected populations from two previously high malaria endemic areas of Sri Lanka. PLoS One [Internet]. 2017 Feb 2;12(2):e0171208. [CrossRef]
- Dewasurendra RL, Rockett KA, Fernando S, Carter R, Kwiatkiwski DC, Karunaweera ND. G6PD gene variants and its association with malaria in a Sri Lankan population. Springer Nat. 2015. [CrossRef]
- Gómez-Manzo S, Marcial-Quino J, Vanoye-Carlo A, Serrano-Posada H, Ortega-Cuellar D, González-Valdez A, et al. Glucose-6-Phosphate Dehydrogenase: Update and Analysis of New Mutations around the World. Int J Mol Sci. 2016 Dec;17(12). [CrossRef]
- Zahidin NS, Saidin S, Zulkifli RM, Muhamad II, Ya’akob H, Nur H. A review of Acalypha indica L. (Euphorbiaceae) as traditional medicinal plant and its therapeutic potential. J Ethnopharmacol [Internet]. 2017;207:146–73. Available online: https://www.sciencedirect.com/science/article/pii/S037887411632445X.
- Sinha T, Bandyopadhyay A. Ethno-Pharmacological Importance and Valuable Phytochemicals of Acalypha indica (L.) - A Review. Int J Res Pharm Sci. 2012;3(3).
- Ma YT, Chuang JI, Lin JH. Phenolics from Acalypha indica. J Chinese Chem Soc. 1997;44(5):499–502. [CrossRef]
- Kavitha S, Kovan TK, Vijaya BR. In Vitro Antioxidant and Anticancer Studies on the Leaf of Acalypha indica. Biomed Pharmacol. 2009;2(2).
- Lee SWH, Lai NM, Chaiyakunapruk N, Chong DWK. Adverse effects of herbal or dietary supplements in G6PD deficiency: a systematic review. Br J Clin Pharmacol. 2017 Jan;83(1):172–9. [CrossRef]
- Kusumoto S, Nakajima T. Methhemoglobin Formation by Aminophenol and Diphenol in Rabbits. Ind Health. 1964;2:133–8. [CrossRef]
- Alanazi MQ. Drugs may be Induced Methemoglobinemia. J Hematol Thrombo Dis. 2017;5(3).
- Pradoo A, Sriapha C, Trakulsrichai S, Tongpoo A, Kheiawsawang M, Wananukul W. Clinical Characteristics of Acalypha indica Poisoning. Int J Gen Med. 2020;13:539–45. [CrossRef]
- Ehelepola NDB, Abayagunawardana AN, Sudusinghe TN. A vegetable-induced hemolytic crisis in a G6PD deficient person: a case report. BMC Res Notes [Internet]. 2018;11(1):179. [CrossRef]
- Durasnel P, Tantet C, Chamouine A, Blondé R. [Plant Traditional Treatment with Acalypha indica Inducing Haemolysis in Patients with G6PD Deficiency: A Frequent Circumstance in Mayotte?]. Bull Soc Pathol Exot. 2018;111(2):81–3. [CrossRef]
- Sathya M, Teepa A. Acute and subacute toxicity studies of Ethanolic extract of Acalypha indica Linn in male Wistar Albino rats. In 2012.
|
Disclaimer/Publisher’s Note: The statements, opinions and data contained in all publications are solely those of the individual author(s) and contributor(s) and not of MDPI and/or the editor(s). MDPI and/or the editor(s) disclaim responsibility for any injury to people or property resulting from any ideas, methods, instructions or products referred to in the content. |
© 2024 by the authors. Licensee MDPI, Basel, Switzerland. This article is an open access article distributed under the terms and conditions of the Creative Commons Attribution (CC BY) license (http://creativecommons.org/licenses/by/4.0/).